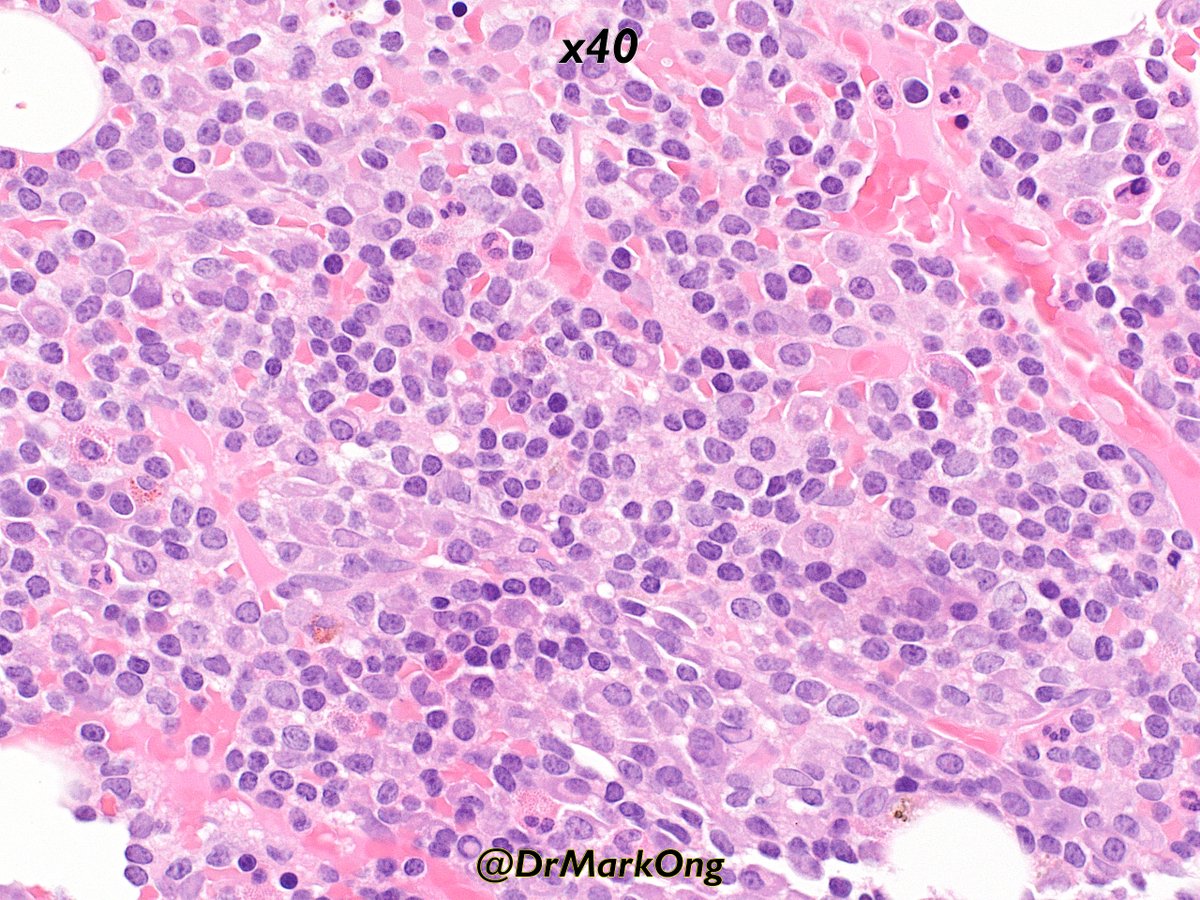
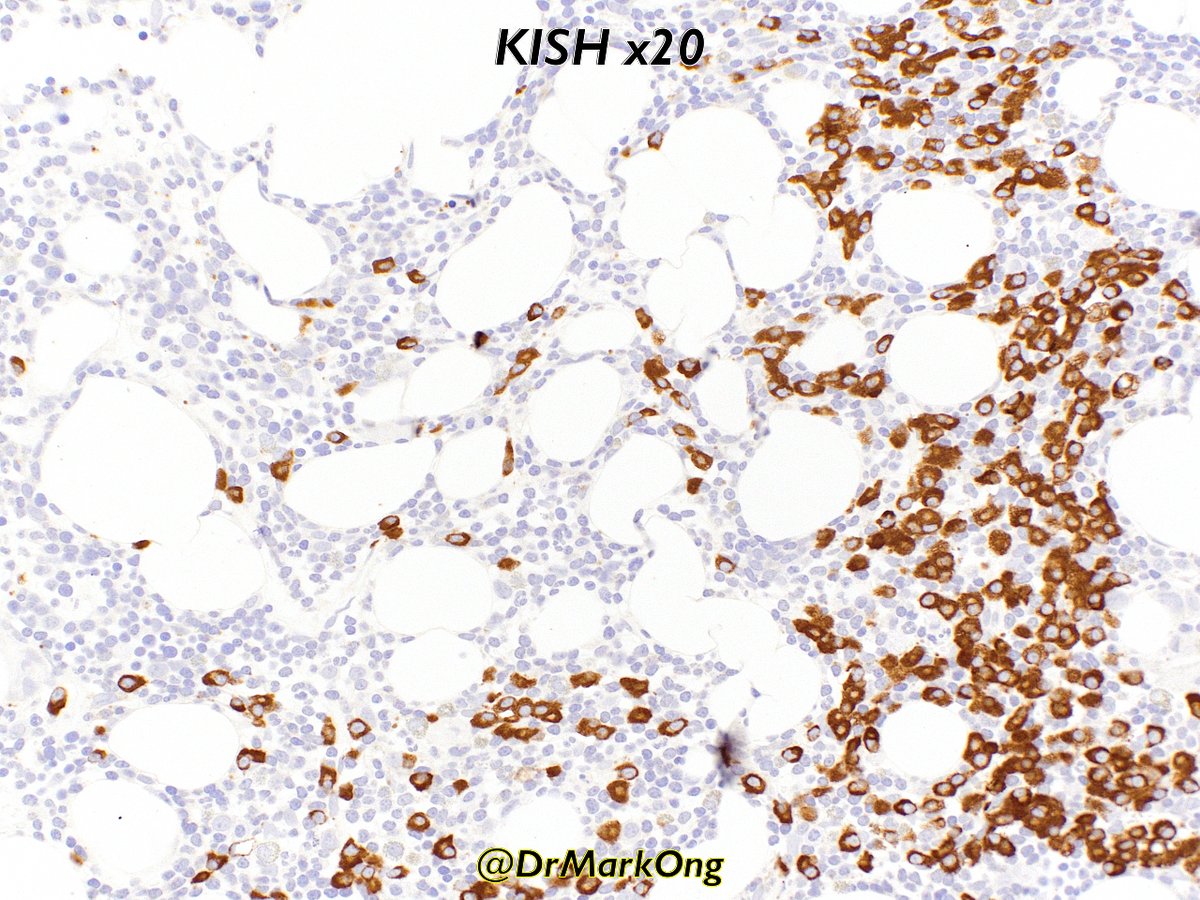

Adult with IgM paraprotein. Case courtesy @YurinaMiki
Bone marrow aspirate flow cytometry.
SS = side scatter = optical complexity of cytoplasm (lymphocytes⬇️, neutrophils⬆️)
FS = forward scatter = size of cell
Small cells with low SS = too many lymphoid cells (64%)
#hemepath


Let’s look at the lymphocyte “gate”.
This plot is a bit confusing as both CD4 & CD19 use the same fluorescent tag. Right half of plot are CD3+ T-cells, divided into CD4+ (top right, cyan) and CD4-(bottom right, maroon).
Red population represents CD19+ B-cells (72% of 64%).

Here, blue = T-cells, red = B-cells.
B-cells are CD5+ CD23+ FMC7- CD79b+
FMC7 is an epitope of CD20:
https://t.co/1LWOax24QB
If FMC7 is all positive or negative, it supports a clonal prolif. Of note, CLL is typically negative for FMC7 and is part of the Matutes CLL score.
https://doi.org/10.1182/blood-2007-11-126243




Matutes scoring is out of 5:
CD5+ = 1 point
CD23+ = 1 point
FMC7- = 1 point
CD22 or CD79b weak/neg = 1 point
Low surface immunoglobin expression = 1 point
Scores of 4 or 5 strongly support a diagnosis of CLL.
https://t.co/Kc0b6WGDKr
https://pmid.us/7523797
https://pmid.us/9322589
Here is the light chain expression??
For Matutes scoring, “low” expression is not well-defined, but I’d consider this case to be at the lower end.
Overall Matutes score is about 4/5, supportive of a diagnosis of CLL.

The immunophenotype in the bone marrow trephine was similar with immunohistochemistry??




What about the IgM kappa paraprotein?
IgM secretion is typically associated with Waldenström’s/lymphoplasmacytic lymphoma, but a range of other lymphomas can secreted Ig. CLL is probably the next most common after LPL.
https://t.co/soTqtu7U6u
https://pmid.us/11707811
https://pmid.us/15842043

However, a few things didn’t add up.
Firstly, as noted above, paraprotein levels >3g/L were restricted to LPL. Levels in this case were >35g/L.
Secondly, the WBC was only 3.0. Given the B-cell numbers in the marrow, the absence of a leukaemic component is very unusual.
?
Here is the bone marrow trephine. Note a mix of plasma cells (with paranuclear hofs & occasional Dutcher bodies), but also some lymphoid cells.
This is not the typical small/medium CLL cells with coarse clumped chromatin.

CD79a highlights both lymphoid & plasmacytic components. Note IgM kappa restriction (ISH = in situ hybridisation).
Mutational analysis demonstrated MYD88 L265P mutation as well as a CXCR4 mutation.
Final diagnosis: Lymphoplasmacytic lymphoma (with CLL immunophenotype!)

The L265P MYD88 mutation is present in >90% of LPL, whilst CXCR4 is present in about 25-30%:
https://t.co/Dg8am6biI0
The L265P is not specific for LPL as it can be seen in DLBCL, but in the context of the IgM paraprotein and morphology, it supports a diagnosis of LPL.
https://doi.org/10.1182/blood-2013-09-525808
The presence of both MYD88 L265P and CXCR4 mutations is associated with higher disease activity (as suggested by bone marrow disease bulk and corresponding cytopaenia):
https://doi.org/10.1111/bjh.13361
